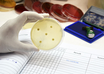

CSIR’s new patented Clot buster, PEGylated Streptokinase set to revolutionize the treatment of Strokes.
M3 India Newsdesk | Aug 14, 2018
Marijuana safe to treat epilepsy in kids: Study
IANS | Aug 14, 2018
Hypertension in pregnancy increases risk of autism, ADHD in kids: JAMA
ANI | Aug 14, 2018
Inappropriate medication linked to higher risk of fracture, mortality
ANI | Aug 13, 2018
Coronary artery compression in kids more common than previously believed
ANI | Aug 13, 2018
Study provides clue to prevent low blood sugar in diabetics
ANI | Aug 13, 2018
Dietary carbohydrate composition could lead to osteoarthritis: Study
ANI | Aug 13, 2018
Blood test may predict kidney cancer risk 5 years in advance
ANI | Aug 13, 2018
Antibiotic resistance genes in air pose threat to human health: Study
IANS | Aug 13, 2018
MIT develops new AI technique to make cancer treatment less toxic
IANS | Aug 13, 2018
Most read this week